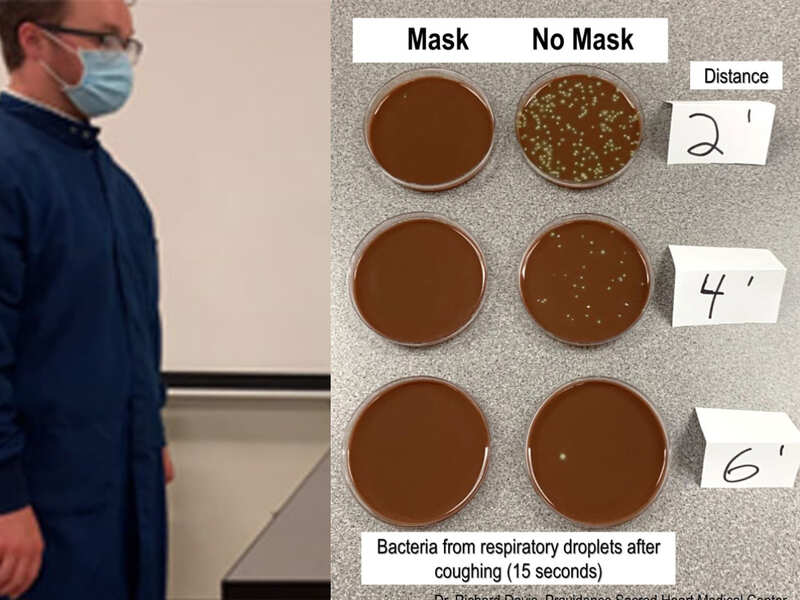

Was Covid 19 An Experiment

How Big Gatherings Spread Covid 19 German Scientists Stage Concert Experiment Times Of India
timesofindia.indiatimes.com

See How Easily Covid 19 Could Spread Through A Restaurant In This Black Light Experiment
www.mytwintiers.com


Ethics Around Businesses Marketing Unproven And Unlicensed Covid 19 Stem Cell Based Therapies University Of Minnesota
twin-cities.umn.edu

Coronavirus Survivor Donates Plasma In Experiment That Could Thwart The Pandemic Orange County Register
www.ocregister.com

Paranoid About The Pandemic How Covid 19 Brought The Largest Criminology Experiment In History National Post
nationalpost.com
:strip_exif(true):strip_icc(true):no_upscale(true):quality(65)/cloudfront-us-east-1.images.arcpublishing.com/gmg/D4JXVJM2TJCIPJBHOREF27RPHU.jpg)
Seminole County Sheriff S Office Vehicle Used In Ford S Experiment To Neutralize Covid 19
www.clickorlando.com

Nh Primary Source Bolduc Backs Theory That Covid 19 Began As Chinese Biological Experiment
www.wmur.com

Belgian Students To Self Collect Saliva In Large Covid 19 Testing Experiment World News The Journal Pioneer
www.journalpioneer.com

Novocellbio In Korea Confirms Novo Nk S Promising Antiviral Effects Against Covid 19 Business Wire
www.businesswire.com

Black Light Experiment Shows How Quickly A Virus Like Covid 19 Can Spread At A Restaurant The Atlanta Voice
www.theatlantavoice.com

Belgian Students To Self Collect Saliva In Large Covid 19 Testing Experiment World The Jakarta Post
www.thejakartapost.com











/arc-anglerfish-arc2-prod-sltrib.s3.amazonaws.com/public/HCK4ITZ64NDH3PMHRLPT6BUCMQ.jpg)












/cdn.vox-cdn.com/uploads/chorus_image/image/66731712/AP20113736200529.0.jpg)














/cdn.vox-cdn.com/uploads/chorus_asset/file/21836402/1054465140.jpg.jpg)

/cloudfront-us-east-1.images.arcpublishing.com/dmn/Y5YWWO2YFVBQ3JNPCGIUTHKOQQ.JPG)














